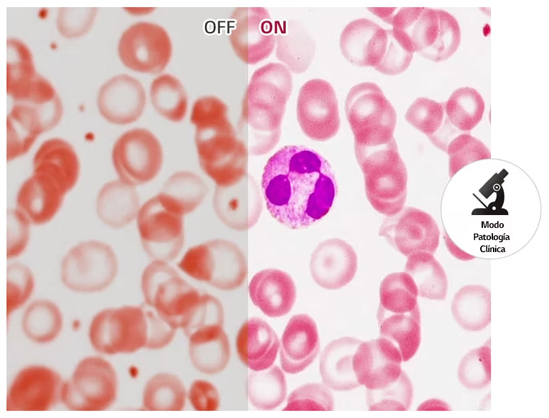

Monitor de Diagnóstico LG 8MP 31.5″ para Radiología General
32HL512D
- Pantalla IPS de 31.5 pulgadas
- Modo de resolución múltiple
- PBP / Controlador Dual
- Calibración de la auto-luminancia
- Modo de patología clínica
- Diseño ergonómico
DESCRIPCIÓN
Pantalla médica LG
Monitor de diagnóstico de 31.5 (80.01cm) 8MP
El modo Down & Wall Lighting reduce el contraste entre la luz del monitor y la luz del entorno, permitiéndole trabajar más cómodamente sin tener que ajustar la luz para ver diferentes documentos.

Calidad de imagen Optimizada para
Revisado Diagnóstico
Pantalla Nano IPS de 31.5 (80.01cm) 8MP
Imagen Precisa Desde Cualquier Ángulo
La pantalla Nano IPS de 31.5 (80.01cm) 8MP facilita diagnósticos precisos de imágenes médicas. El amplio ángulo de visión de 178° permite a los pacientes y a los médicos ver imágenes reproducidas con precisión y con una distorsión mínima.


Modo de Resolución Múltiple
Compatible con todos los dispositivos
La conexión a los diversos tipos de dispositivos es esencial para el monitor de diagnóstico. Gracias al modo multiresolución de 32HL512D, puedes ajustar la resolución del monitor para optimizarla al dispositivo conectado.
Modo de Patología Clínica
Reproducción Realista de Colores
Como el monitor LG 32HL512D adopta el modo de patología clínica con una mejor reproducción de colores, puede entregar imágenes del microscopio de forma vívida sin distorsión del color.

Calibración de Luminancia Automática
Calidad de Imagen Sostenida
La calibración automática de luminancia incorporada ayuda a aumentar la productividad y eficiencia. Convierte las imágenes médicas a imágenes más apropiadas de manera automática para elaborar un diagnóstico exacto.
Para Aumentar la Eficiencia y
Comodidad
PBP y Controlador Dual
Varias Señales en una Pantalla
PBP (Picture By Picture) con Dual Controller, controla múltiples dispositivos conectados a una pantalla con un teclado o mouse, ayuda a aumentar la conveniencia en la evaluación. Puede revisar múltiples informaciones en paralelo en una pantalla.

Diseño Ergonómico
Diseñado para la Comodidad e Inmersión
Su soporte ergonómico, su ajuste de pivote bidireccional y su estrecho bisel permiten realizar un espacio de trabajo de diagnóstico optimizado. Gire dos monitores en vertical y úselos uno al lado del otro para obtener la mejor experiencia de lectura.


ESPECIFICACIONES
Pantalla
| Tamaño (pulgadas) | 31.5 | Ángulo de Visión (CR≥10) | 178º(D/I), 178º(Arriba/Abajo) |
| Resolución | 3840 x 2160 | Tratamiento superficial | Anti-reflejos |
| Ratio de Aspecto | 16:9 | Tamaño de píxel | 0.18159 x 0.18159 mm |
| Brillo (Tip.) | 450 cd/m² | Gama de Color (Tip.) | DCI-P3 98% (CIE1976 |
| Color bit | 10bit (8bit+FRC) | Ratio de contraste (Tip.) | 1300:1 |
| Tiempo de respuesta | 5ms (GtG a máx. Velocidad) |
Características
| Sensor de Luz Automático | Sí | Estabilizador de Negros | Sí |
| DICOM | Sí (<=10%) | Ángulo de Visión (CR≥10) | 178(I/D), 178(Arr./Ab.) |
| Sensor frontal | Sí | HDR 10 | Sí |
| Autocalibración HW | Sí (PerfectLum) | Encendiendo | Sí |
| PBP | SÍ (2PBP) | Ahorro de energía inteligente | Sí |
| Estabilizador de brillos | Sí | Uniformidad | Sí |
| Idioma OSD | 17 idiomas | Modo de imagen | (SDR) Personalizado, Mono, Patología, Lector, Vívido, Efecto HDR, DICOM (Clínico), DICOM (Diagnóstico), Calibración 1, Calibración 2, (HDR) Personalizado, Vívido, Estándar |
| Modo Lectura | Si | Iluminación | Si(Inferior/ Trasera) |
| Modo Patológico | Sí | Super Resolution+ | Sí |
Aplicación SW
| Qubyx | Sí | Doble Control | Sí |
| Controles en la pantalla (LG Screen Manager) | Sí |
Conectividad
| Versión DP | 1.4 | Puerto de visualización | Sí (2cu) |
| HDMI | SI(1cu) | Versión HDMI | 2.0 |
| Puerto de Descarga USB | Sí (2cu/ver2.0) | Puerto de envío USB | Sí (1cu/ver2.0) |
Energía
| Tipo | Energía externa (Adaptador) | Entrada de AC | 100-240Vac, 50/60Hz |
| Consumo de energía (Max.) | 65W | Salida CC | 19V, 3.42A |
| Consumo de Energía (C/C apagado) | Menos de 0.3W | Consumo de Energía (Modo de Espera) | Menos de 1.2W |
Mecánico
| Ajustes de posición de pantalla | Inclinación/Altura/Giro | Montaje en pared | 100 x 100 mm |
| Rango de altura | 0~110mm | Giro | Bi-Dirección |
| Inclinacion | Sí | Altura baja | 85.3 |
Dimensión/Peso
| Dimensión con Base (A x A x P) | 718.2 X 598.0 X 231.2 mm (Arriba) 718.2 X 488.0 X 231.2 mm (Abajo) | Dimension sin Base (A x A x P) | 718.2 X 414.3 X 45.1 mm |
| Dimensiones para Envío (A x A x P) | 822 X 537 X 215 mm | Peso con base | 7,3kg |
| Peso sin Base | 5.9kg |






